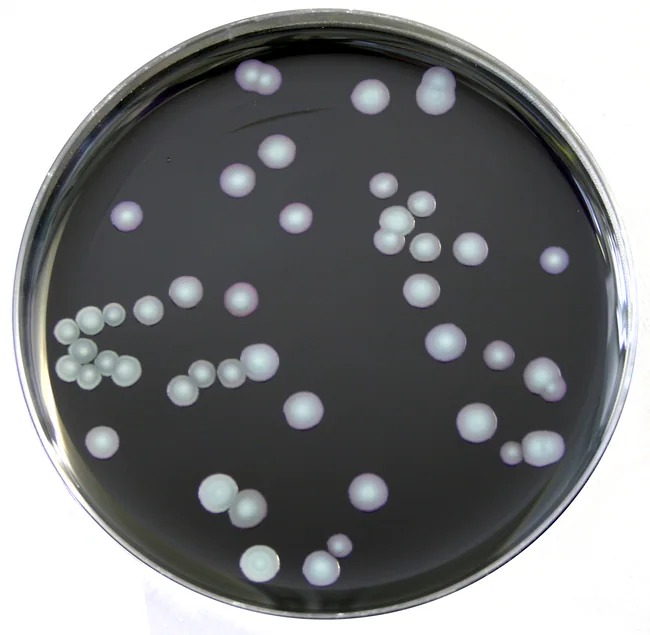

Description
Thermo Scientific offers a robust and comprehensive portfolio of microbial culture solutions, meticulously engineered to meet the stringent requirements of modern laboratories across the food, clinical, and pharmaceutical sectors. By providing a diverse array of formats—ranging from high-quality dehydrated culture media and supplements to ready-to-use prepared plates and convenience-oriented bagged media—these products ensure that every lab can achieve a seamless and efficient workflow. With over a century of specialized expertise in microbiology, the Thermo Scientific brand represents a commitment to quality and innovation, offering a culture you can trust for critical testing and identification.
The collection features state-of-the-art technologies such as the automation-compatible SmartPlate design and advanced atmosphere generation systems, which are essential for the successful cultivation of anaerobic and microaerophilic organisms. These solutions are specifically designed to enhance laboratory productivity, significantly reducing manual preparation time and minimizing environmental waste through systems like the Tailored Delivery Solution. Whether performing routine quality control, identifying pathogens, or conducting complex environmental monitoring, researchers and technicians can rely on these consistent, high-performance tools to deliver accurate results and maintain compliance with industry standards.
Key Features:
Comprehensive selection of dehydrated and prepared culture media
Strict quality standards ensuring batch-to-batch consistency
Innovative SmartPlate design for automation compatibility
Versatile atmosphere generation systems for diverse incubation needs
Convenient enrichment formats including FitBag and QuickBag
Tailored Delivery Solution to reduce inventory costs and waste
High-performance chromogenic media for rapid identification
Extensive range of animal-free formulations and supplements
Reliable quality control organisms with Culti-Loops technology
Integrated workflows for food safety and clinical diagnostics